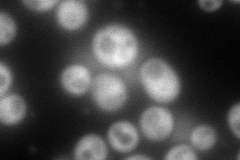
YDR516C
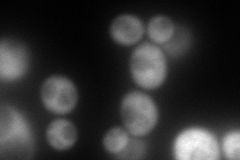
YDR516C
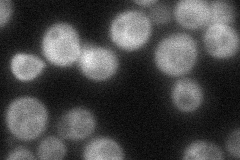
YDR516C
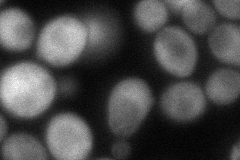
YDR516C
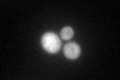
YDR516C
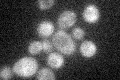
YDR516C
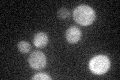
YDR516C

View description
Non-essential protein of unknown function required for transcriptional induction of the early meiotic-specific transcription factor IME1; required for sporulation; expression is regulated by glucose-repression transcription factors Mig1/2p
Localization:
Intensity:
Fold change:
Significance:
-
C’ GFP library in SD

cytosol41.66 -
N' NOP1pr-GFP in SD
cytosol205.545 -
N' TEF2pr-mCherry in SD
cytosol230.281 -
N' NATIVEpr-GFP in SD
cytosol48.2583 -
N' TEF2pr-VC and Cyto-VN in SD
cytosol80.127 -
C’ GFP library in SD+DTT
cytosol52.161.25No -
C’ GFP library in SD+H2O2
cytosol40.770.97No -
C’ GFP library in Starvation Media
cytosol36.050.86No -
C’ GFP library on the background of Pup2-DaMP

cytosol -
C’ GFP library on the background of CCT mutant

cytosol64.22311.54129Yes
